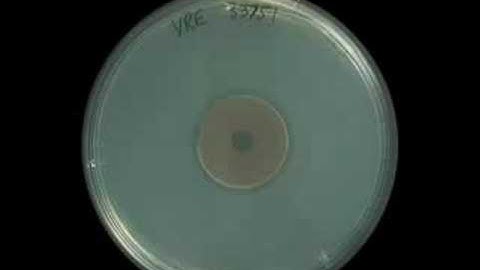
Enterococcus faecalis (VRE) - Zonex

⬇ DOWNLOAD NOW
Kalau muncul iklan pop-up, tutup lalu klik tombol kembali
Download lagu A quicker way to track down enterococci secara gratis hanya untuk keperluan promosi. Dukung artis favorit kamu dengan membeli musik original di iTunes atau platform resmi lainnya.
 Motile Enterococcus: E gallinarium
Motile Enterococcus: E gallinarium
 Infectious Disease, Enterococci Bacteremia
Infectious Disease, Enterococci Bacteremia
Enterococcus faecalis (VRE) - Zonex
Enterococcus faecalis (VRE) - Zonex
 Streak Plate Technique for The Isolation of Pure Culture_A Complete Procedure (Microbiology)
Streak Plate Technique for The Isolation of Pure Culture_A Complete Procedure (Microbiology)
 Enterococcus Meaning
Enterococcus Meaning
 Natural Antibiotics for C. Difficile Infection (Clostridium Difficile) - Dr.Berg
Natural Antibiotics for C. Difficile Infection (Clostridium Difficile) - Dr.Berg
 Enterococcus infection 🔊
Enterococcus infection 🔊
 Enterococcus- causes, symptoms, diagnosis, treatment, pathology
Enterococcus- causes, symptoms, diagnosis, treatment, pathology